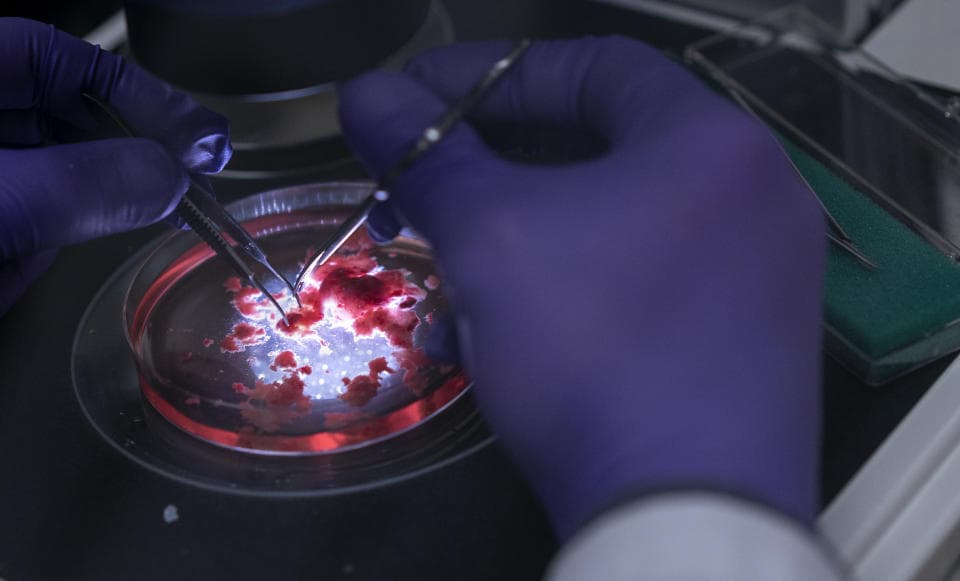
Οι ερευνητές συνδυάζουν ανθρώπινο εγκεφαλικό ιστό που έχει αναπτυχθεί στο εργαστήριο με ηλεκτρονικά, Οι ερευνητές συνδυάζουν ανθρώπινο εγκεφαλικό ιστό που έχει αναπτυχθεί στο εργαστήριο με ηλεκτρονικά, TechWar.gr

Οι ερευνητές συνδυάζουν ανθρώπινο εγκεφαλικό ιστό που έχει αναπτυχθεί στο εργαστήριο με ηλεκτρονικά
Σε μια ιστορία που βγήκε από
τι
ς πρώτες σκηνές μιας ταινίας τρόμου επιστημονικής φαντασίας, οι
επιστήμονες
γεφύρωσαν ένα κρίσιμο χάσμα μεταξύ βιολογικού και ηλεκτρονικού. Η μελέτη,
δημοσίευσε
σε
Nature Electronics
(
συνοψίζονται
σε
Φύση
), περιγράφει λεπτομερώς έναν «υβριδικό βιοϋπολογιστή» που συνδυάζει ανθρώπινο εγκεφαλικό ιστό που έχει αναπτυχθεί στο εργαστήριο με συμβατικά κυκλώματα και τεχνητή νοημοσύνη. Με το όνομα Brainoware, το σύστημα έμαθε να αναγνωρίζει φωνές με ακρίβεια 78%. Θα μπορούσε μια μέρα να οδηγήσει σε μικροτσίπ πυριτίου συγχωνευμένα με νευρώνες.
Το Brainoware συνδυάζει οργανοειδή του εγκεφάλου – συστάδες ανθρώπινων κυττάρων που προέρχονται από βλαστοκύτταρα που μεταμορφώνονται σε “μίνι εγκεφάλους” γεμάτους νευρώνες – με συμβατικά ηλεκτρονικά κυκλώματα. Για να το φτιάξουν, οι ερευνητές τοποθέτησαν «ένα μόνο οργανοειδές σε μια πλάκα που περιείχε χιλιάδες ηλεκτρόδια για τη σύνδεση του εγκεφάλου με τα ηλεκτρικά κυκλώματα». Τα κυκλώματα, μιλώντας στο οργανοειδές του εγκεφάλου, «μεταφράζουν τις πληροφορίες που θέλουν να εισαγάγουν σε ένα μοτίβο ηλεκτρικών παλμών».
Στη συνέχεια, ο εγκεφαλικός ιστός μαθαίνει και επικοινωνεί με την
τεχνολογία
. Ένας αισθητήρας στην ηλεκτρονική συστοιχία ανιχνεύει την απόκριση του μίνι εγκεφάλου, την οποία αποκωδικοποιεί ένας εκπαιδευμένος αλγόριθμος μηχανικής μάθησης. Με άλλα λόγια, με τη βοήθεια του AI, οι νευρώνες και τα ηλεκτρονικά συγχωνεύονται σε μια ενιαία (εξαιρετικά βασική, προς το παρόν) βιομηχανή επίλυσης προβλημάτων.
Οι ερευνητές δίδαξαν το σύστημα υπολογιστή-εγκεφάλου να αναγνωρίζει τις ανθρώπινες φωνές. Εκπαίδευσαν την Brainoware σε 240 ηχογραφήσεις οκτώ ατόμων που μιλούσαν, «μεταφράζοντας τον ήχο σε ηλεκτρικό για να παραδοθεί στο οργανοειδές». Το οργανικό μέρος αντέδρασε διαφορετικά σε κάθε φωνή, ενώ δημιουργούσε ένα μοτίβο νευρικής δραστηριότητας που έμαθε να κατανοεί η τεχνητή νοημοσύνη. Η Brainoware έμαθε να αναγνωρίζει τις φωνές με ακρίβεια 78%.
(Η Washington Post μέσω Getty Images)
Η ομάδα βλέπει το έργο ως περισσότερο απόδειξη της ιδέας παρά κάτι με βραχυπρόθεσμη πρακτική χρήση. Αν και προηγούμενες μελέτες
έδειξε
δισδιάστατες καλλιέργειες κυττάρων νευρώνων θα μπορούσαν να κάνουν παρόμοια πράγματα, αυτή είναι η πρώτη δοκιμή που χρησιμοποιεί ένα εκπαιδευμένο τρισδιάστατο κομμάτι ανθρώπινων εγκεφαλικών κυττάρων. Θα μπορούσε να δείχνει ένα μέλλον βιολογικών υπολογιστών, όπου η «ταχύτητα και η αποτελεσματικότητα του ανθρώπινου εγκεφάλου» πυροδοτούν μια υπερδύναμη τεχνητή νοημοσύνη. (Τι μπορεί να πάει στραβά;)
Ο Arti Ahluwalia, βιοϊατρικός μηχανικός στο Πανεπιστήμιο της Πίζας της Ιταλίας, βλέπει την τεχνολογία να ρίχνει περισσότερο φως στον ανθρώπινο εγκέφαλο. Δεδομένου ότι τα οργανοειδή του εγκεφάλου μπορούν να αντιγράψουν το κέντρο ελέγχου του νευρικού συστήματος με τρόπους που οι απλές κυτταρικές καλλιέργειες δεν μπορούν, ο ερευνητής θεωρεί το Brainoware (και τις περαιτέρω προόδους που θα μπορούσε να γεννήσει) ως βοηθητικό
μοντέλο
και μελέτη νευρολογικών διαταραχών όπως το Αλτσχάιμερ. «Εκεί είναι η υπόσχεση. χρησιμοποιώντας αυτά για να αντικαταστήσει μια μέρα τα ζωικά μοντέλα του εγκεφάλου», είπε ο Ahluwalia
Φύση
.
Οι προκλήσεις για την περίεργη τεχνολογία πρωτο-κυβόργκ περιλαμβάνουν τη διατήρηση των οργανοειδών ζωντανών, ειδικά όταν μετακινούνται σε πιο σύνθετες περιοχές όπου οι επιστήμονες θέλουν τελικά να τα αναπτύξουν. Τα εγκεφαλικά κύτταρα πρέπει να αναπτυχθούν σε μια θερμοκοιτίδα, κάτι που θα μπορούσε να γίνει πιο δύσκολο με μεγαλύτερα οργανοειδή. Τα επόμενα βήματα περιλαμβάνουν την
εργασία
για να μάθουμε πώς τα οργανοειδή του εγκεφάλου προσαρμόζονται σε πιο σύνθετες εργασίες και τη μηχανική τους για μεγαλύτερη σταθερότητα και αξιοπιστία.
VIA:
engadget.com

